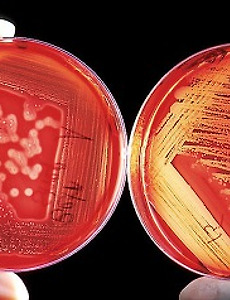

금연후 몸의변화 주기별로 확인하기
금연후 몸의변화 주기별로 확인하기 연말연시가 다가오고, 새해가 다가오고 하면 꼭 하게 되는 결심 중 금연, 다이어트, 외국어 마스터 등은 단골 손님입니다. 담배를 끊는 사람하고는 상종도 하지 말라 했다는데 그만큼 힘들다는 뜻이겠죠? 그럼에도 연예인들 보면 꽤 많은 사람들이 금연을 몇년째 이어가고 있는 사람들이 많더라구요. 금연후 몸의변화 어떻게 나타날까요? 주기별로 확인해볼까 합니다. 우선 담배가 원인 중 하나인 질환에는 어떤 것이 있는지 잠시 살펴볼까 합니다. 어떤 폐해가 있는지 보고 그리고 금연후 몸의변화 어떻게 나타나는지 본다면 끊고 싶어지지 않을까 싶기도 합니다. 그럼 담배가 원인 중 하나인 질환 먼저 암에는 방광암, 자궁경부암, 식도암, 인두암, 구강암, 폐암, 췌장암, 위암, 백혈병 등이 있습..
2019. 11. 10.
금연후 몸의변화 주기별로 확인하기
금연후 몸의변화 주기별로 확인하기 연말연시가 다가오고, 새해가 다가오고 하면 꼭 하게 되는 결심 중 금연, 다이어트, 외국어 마스터 등은 단골 손님입니다. 담배를 끊는 사람하고는 상종도 하지 말라 했다는데 그만큼 힘들다는 뜻이겠죠? 그럼에도 연예인들 보면 꽤 많은 사람들이 금연을 몇년째 이어가고 있는 사람들이 많더라구요. 금연후 몸의변화 어떻게 나타날까요? 주기별로 확인해볼까 합니다. 우선 담배가 원인 중 하나인 질환에는 어떤 것이 있는지 잠시 살펴볼까 합니다. 어떤 폐해가 있는지 보고 그리고 금연후 몸의변화 어떻게 나타나는지 본다면 끊고 싶어지지 않을까 싶기도 합니다. 그럼 담배가 원인 중 하나인 질환 먼저 암에는 방광암, 자궁경부암, 식도암, 인두암, 구강암, 폐암, 췌장암, 위암, 백혈병 등이 있습..
2019. 11. 10.